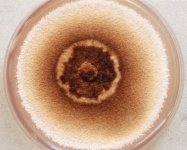

<< back to search
IMAGES:








Search Details
add to cart
| UAMH Number: | 10106 |
|---|---|
| Species Name: | Pezicula brunnea |
| Type: | Cryptosporiopsis brunnea |
| Synonyms: | Cryptosporiopsis brunnea |
| Taxonomy: | FUNGI Ascomycota, Leotiomycetes, Helotiales, Dermateaceae |
| Strain History: | Allen, T.R. (UBCtra 288) -> UAMH |
| Substrate: | root of Gaultheria shallon | Location: | CANADA British Columbia, Vancouver Island, north island (GEO: 49.651,-125.449) |
| Isolator: | T.R. Allen |
| Isolation Date: | 1998-05-01 |
| Date Received: | 2001-12-07 |
| Characters: | CULTURE CONDITIONS morphology of conidiomata by SEM - Wang W, Mycology 2:237-247, 2011 // MOLECULAR SYSTEMATICS clustered with low support to Cryptosporiopsis radicicola - Verkeley et al., Mycol. Res. 107:689-698, 2003 // MOLECULAR SYSTEMATICS DNA and culture-based detection of ericoid mycorrhizal fungi - Allen TR, Millar T, Berch SM, Berbee ML, New Phytologist 160:255-272, 2003 // MOLECULAR SYSTEMATICS phylogeny of ericoid mycorrhizal fungi - Berch S, Allen TR, Berbee ML, Plant and Soil 244:55-66, 2002 // MOLECULAR SYSTEMATICS root associated Cryptosporiopsis species - Sigler L, Allen TR, Lim SR, Berch S, Berbee M, Stud. Mycol. 53:53-62, 2005 // MYCORRHIZAE ericoid endophyte, not mycorrhizal in resynthesis - Berch S, Allen TR, Berbee ML, Plant and Soil 244:55-66, 2002 (Click for publications citing UAMH 10106) |
| Compounds: | |
| Cross Reference: | CBS 120291 |
| Collections: | Living Strains; Dried Herbarium Material |
| Pathogenic Potential: | Human: no | Animal: no | Plant: yes |
| Biosafety Risk Group: | RG1 (check the PHAC ePATHogen Risk Group Database for updates) |
| Regulatory Requirements: | No restrictions for Canadian requesters. International requesters must provide all legally required importation documentation prior to shipment. Plant pathogenicity status may be verified by using the USDA Agricultural Research Service (ARS) Fungal Database |
| MycoBank ID: | 808965 |
| Sequences: | >UAMH10106_AF149074_SSU-LSU CCTGCGGAGGGATCATTACAGAGACTCTGCCCTTTGGGTAGACCTCCCACCCTGTGTCGTTATACCTTCGTTGCTTTGGCGGGCCGCGGGGCCCCGGCCCTGCCCCTGGCTCCGGCTAGGGCGCGCCCGCCAGAGGACCTCCAAACCTGAACGTTAGTGTCGTCTGAGTACTATATAATAGTTAAAACTTTCAACAACGGATCTCTTGGTTCTGGCATCGATGAAGAACGCAGCGAAATGCGATAAGTAATGTGAATTGCAGAATTCAGTGAATCATCGAATCTTTGAACGCACATTGCGCCCCTTGGTATTCCGGGGGGCATGCCTGTTCGAGCGTCATTACAACCCTCAAGCTCTGCTTGGTCTTGGGCGTCACCGGTCCCCGGTGTGCCCTAAAATCAGTGGCGGCGCCATCTGGCTCTAAGCGTAGTACACACTCTCGCTACAGACGTCCGGTGGATGCTGGCCAGCAACCCCCAATTTATCAAGGTTGACCTCGGATCAGGTAGGGATACCCGCTGAACTTAAGCATATCAATA |
IMAGES: